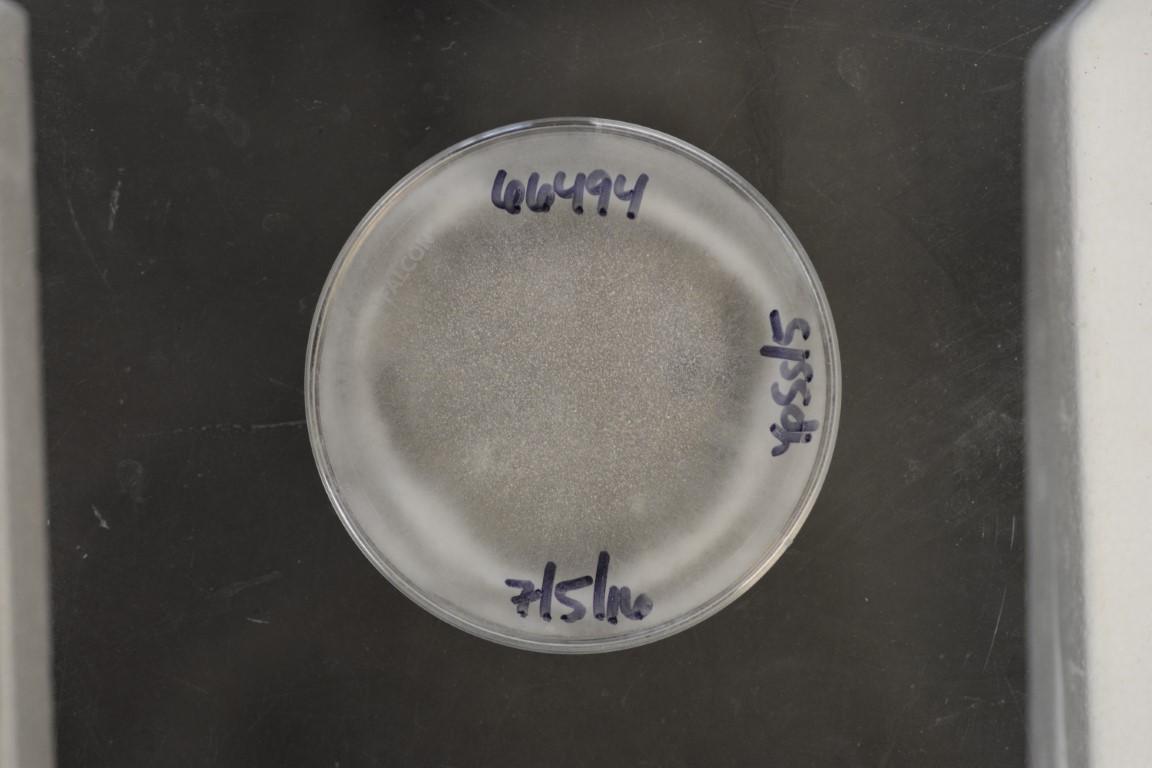

Syncephalis cornu
NRRL 66494(Type Strain)
Accession numbers in other collections:S293
Source:Nicole Reynolds,Plant Pathology Dept,Univ of Florida,Gainesville FL
Isolated from(substrate):Soil from rhizosphere of St.Augustine grass
Substrate location:Florida.Okaloosa County,,USA
Growth media:YpSs/5(number 38)
Optimum growth temperature:25C
Strain images:
NRRL_66494_38.JPG

Comments:Coll 2 June 2004,coll unkown,isol G.L.Benny;host:Zygorhynchus sp
NRRL66494